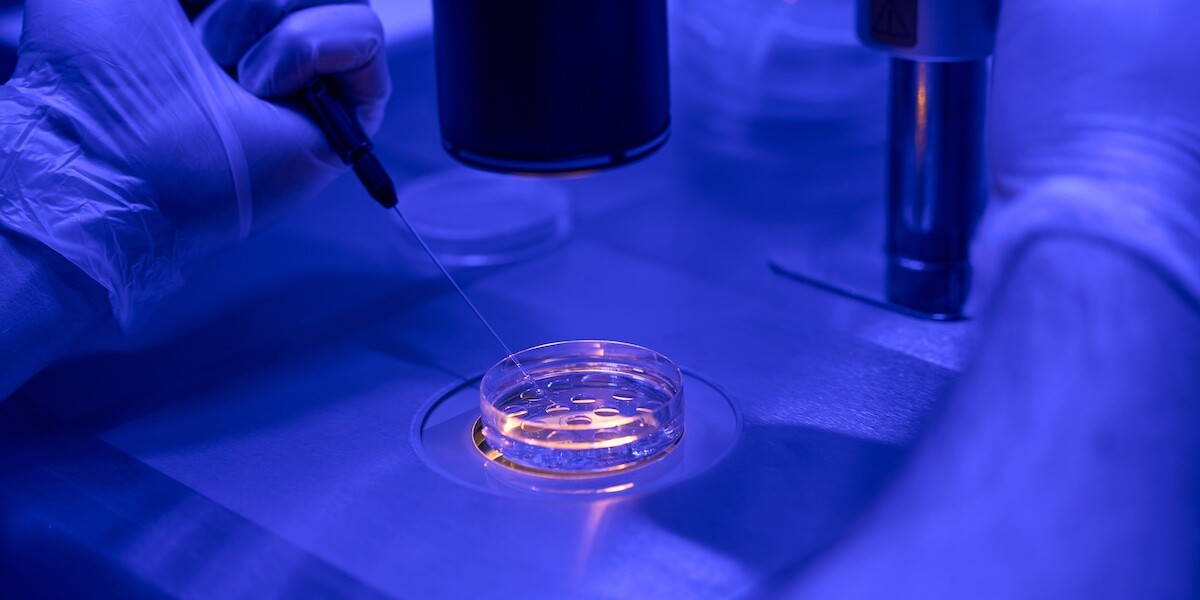

Wensouders die een erfelijke hartziekte hebben, kunnen dankzij een nieuw beslismodel eerder te weten komen of zij in aanmerking komen voor embryoselectie. Het beslismodel is gebaseerd op wetenschappelijke en praktische inzichten en ontwikkeld door onderzoekers van het Maastrichts UMC. Voorheen was een team van specialisten nodig om te bepalen of een koppel in aanmerking kan komen voor embryoselectie. Dankzij het beslismodel kunnen ze bij een positieve uitkomst eerder starten met het traject.
Bij ouders met een genetische afwijking worden embryo’s onderzocht. Deze embryoselectie wordt ook wel een pre-implantatie genetische test (PGT) genoemd. Alleen de embryo’s zonder die afwijking worden in de baarmoeder geplaatst, waardoor de erfelijke aandoening niet wordt doorgegeven. Embryoselectie is alleen toegestaan bij ernstige erfelijke aandoeningen. Denk hierbij aan ziektes die al op jonge leeftijd ernstige beperkingen veroorzaken en moeilijk behandelbaar zijn en waarbij de kans groot is dat de afwijking wordt doorgegeven. Vorig jaar ontwikkelde het MUMC al een nieuwe methode voor embryoselectie.
Embryoselectie bij erfelijke hartziekten
Bij erfelijke hartziekten is het moeilijk om in te schatten of de genetische afwijking ernstig genoeg is voor PGT. Daarom geldt er daarvoor een zogeheten ‘nee, tenzij’-beleid. Dat betekent dat deze erfelijke hartafwijkingen daar in principe niet voor in aanmerking komen, tenzij er verzwarende omstandigheden zijn die het rechtvaardigen om van de 'nee' af te wijken. Dat beleid is er omdat niet iedereen met een genetische aanleg daadwerkelijk ziek wordt, of pas op latere leeftijd (milde) klachten krijgt. Dat kan ook binnen families verschillen.
Mede daarom werd bij erfelijke hartziekten de hulp van een team van specialisten ingeroepen om voor elk individueel koppel te bepalen of zij in aanmerking komen voor PGT. “Maar we weten inmiddels goed onder welke genetische en familiaire omstandigheden de ‘nee, tenzij’ een ‘ja’ wordt”, zegt AIOS klinische genetica gespecialiseerd in erfelijke hartaandoeningen, Job Verdonschot. Dankzij de wetenschappelijke inzichten en de ervaring van het PGT-centrum in Maastricht kunnen ze steeds beter voorspellen wie risico loopt op een ernstige hartziekte en wat het risico is dat hun kinderen daadwerkelijk ziek zullen worden.
Nieuw beslismodel
Verdonschot vertaalde die inzichten naar een beslismodel, waarmee de PGT-werkgroep kan beoordelen wie in aanmerking kunnen komen voor PGT. Met het beslismodel kan voor elk koppel op dezelfde manier en volgens onderbouwde criteria een goede afweging worden gemaakt. Uit het onderzoek van Verdonschot blijkt dat in 95% van de gevallen de beoordeling van het model overeenkwam met die van het medisch team.
Volgens mede-onderzoeker Malou Heijligers, klinisch geneticus gespecialiseerd in PGT, biedt het beslismodel voordelen voor patiënten. Volgens haar is in 9 van de 10 gevallen het nu niet meer nodig dat meerdere specialisten met elkaar overleggen. Heijligers verwacht dat de vraag naar PGT bij hartafwijkingen gaat toenemen. Dat komt volgens haar omdat wensouders nu vaak op eigen initiatief komen omdat ze zich hebben laten informeren over de mogelijkheden van embryoselectie.
Nu de beoordeling voor erfelijke hartaandoeningen is gestandaardiseerd, zou volgens Heijligers het bespreken van PGT een vast onderdeel moeten worden van het cardiologische consult. Op die manier wordt het voor meer patiënten beschikbaar gemaakt. “En voor cardiologen biedt dit een nieuwe behandeloptie voor hun jonge patiënten met een erfelijke hartafwijking”, aldus Heijligers.